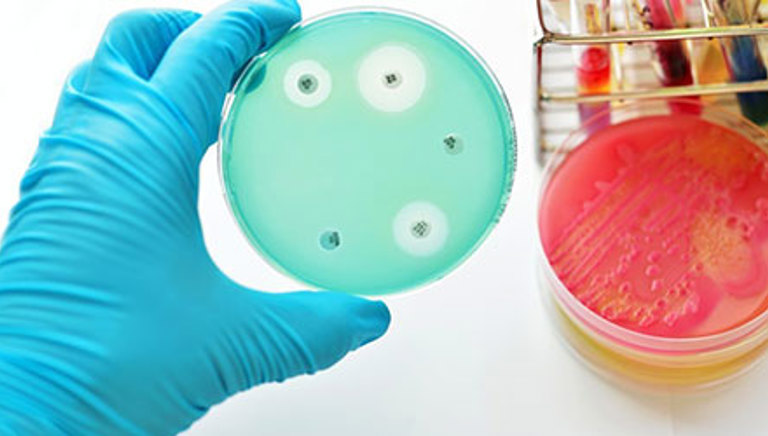
Petri dish

Developing new antibiotics key for the race against resistant infections, says ABPI
World antimicrobial awareness week 18 to 25 November.
Antibiotic resistance is a silent threat to the very foundations of modern medicine. Addressing the challenge will take a global effort and the very important contribution of individual healthcare workers and patients in their use and stewardship of these vital drugs.
In 2019, it was estimated that 1.2 million deaths globally, were due to antibiotic-resistant infections1. In England, during 2019/20, there were over 90,000 hospital admissions2 – yet the global pipeline for new antibiotics to address this growing problem has been failing.
This year’s World Antimicrobial Awareness Week aims to improve the awareness and understanding of antimicrobial resistance (AMR). The event seeks to encourage best practices among the public, health workers and policy makers to avoid the further emergence and spread of antibiotic resistance.
We are now living in an age where drug resistant microbes are developing faster than new antimicrobial treatments, which poses a huge threat to modern medicine.
Amit Aggarwal, Executive Director, Medical Affairs said: “Antibiotic resistance is a silent threat to the very foundations of modern medicine. Addressing the challenge will take a global effort and the very important contribution of individual healthcare workers and patients in their use and stewardship of these vital drugs.
“The UK is already playing a leading role in tackling Antibiotic resistance through changes to how it incentivises and rewards antibiotics innovation, but it cannot win this fight alone. We must continue to spur global efforts to improve how we use existing antibiotics and prioritise the development of new antimicrobial treatments.”
Antibiotic resistance occurs when the bacteria that cause infection no longer respond to available antimicrobial treatments. Every health system in the world depends on the use of antimicrobial treatments, such as antibiotics, which are used in everyday medical care. From tooth extractions and the delivery of chemotherapy to use in routine surgical procedures, and treatment of sepsis, antibiotics represent one of the most powerful tools in modern healthcare.
The threat posed by antibiotic resistance can be avoided, but requires efforts from governments, healthcare workers and pharmaceutical companies around the world. They must come together to:
- protect existing antimicrobial treatments
- collaborate at the global level to develop sustainable long-term solutions for discovering new treatments and bringing these to patients
By coming together, the threat of AMR can be limited and lead to the avoidance of thousands of AMR related deaths.
- AMR
- Anti Microbial Resistance
- Antibiotics
- Antibiotic resistance
Last modified: 20 September 2023
Last reviewed: 20 September 2023